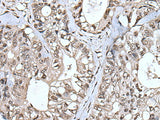
TIA1 Polyclonal Antibody Reactivity Human

TIA1 Polyclonal Antibody Reactivity Human
SKU: E-AB-52223-200
TIA1 Polyclonal Antibody Reactivity Human
| SKU # | E-AB-52223 |
| Reactivity | Human, Mouse |
| Host | Rabbit |
| Applications | WB, IHC |
Product Details
| Isotype | IgG |
| Host | Rabbit |
| Reactivity | Human, Mouse |
| Applications | WB, IHC |
| Clonality | Polyclonal |
| Immunogen | Full length fusion protein |
| Abbre | TIA1 |
| Synonyms | Cytotoxic granule associated RNA binding protein, Cytotoxic granule associated RNA binding protein 1, Nucleolysin TIA 1 isoform p40 , Nucleolysin TIA-1 isoform p40, Nucleolysin TIA1 isoform p40, RNA b, mTIA-1, p40 TIA 1, p40-TIA-1, p40-TIA-1 (containing p15-TIA-1) |
| Swissprot | |
| Calculated MW | 43 kDa |
| Observed MW | Refer to figures |
| Cellular Localization | Cytoplasmic granule. Nucleus. Accumulates in cytoplasmic stress granules (SG) following cellular damage. |
| Concentration | 1 mg/mL |
| Buffer | Phosphate buffered solution, pH 7.4, containing 0.05% stabilizer and 50% glycerol. |
| Purification Method | Antigen affinity purification |
| Research Areas | Cancer, Cell Biology, Epigenetics and Nuclear Signaling, Immunology |
| Conjugation | Unconjugated |
| Storage | Store at -20°C Valid for 12 months. Avoid freeze / thaw cycles. |
| Shipping | The product is shipped with ice pack,upon receipt,store it immediately at the temperature recommended. |
Related Reagents
| Applications | Recommended Dilution |
| WB | 1:1000-1:5000 |
| IHC | 1:40-1:250 |
Background
The product encoded by this gene is a member of a RNA-binding protein family and possesses nucleolytic activity against cytotoxic lymphocyte (CTL) target cells. It has been suggested that this protein may be involved in the induction of apoptosis as it preferentially recognizes poly(A) homopolymers and induces DNA fragmentation in CTL targets. The major granule-associated species is a 15-kDa protein that is thought to be derived from the carboxyl terminus of the 40-kDa product by proteolytic processing. Alternative splicing resulting in different isoforms of this gene product has been described in the literature.